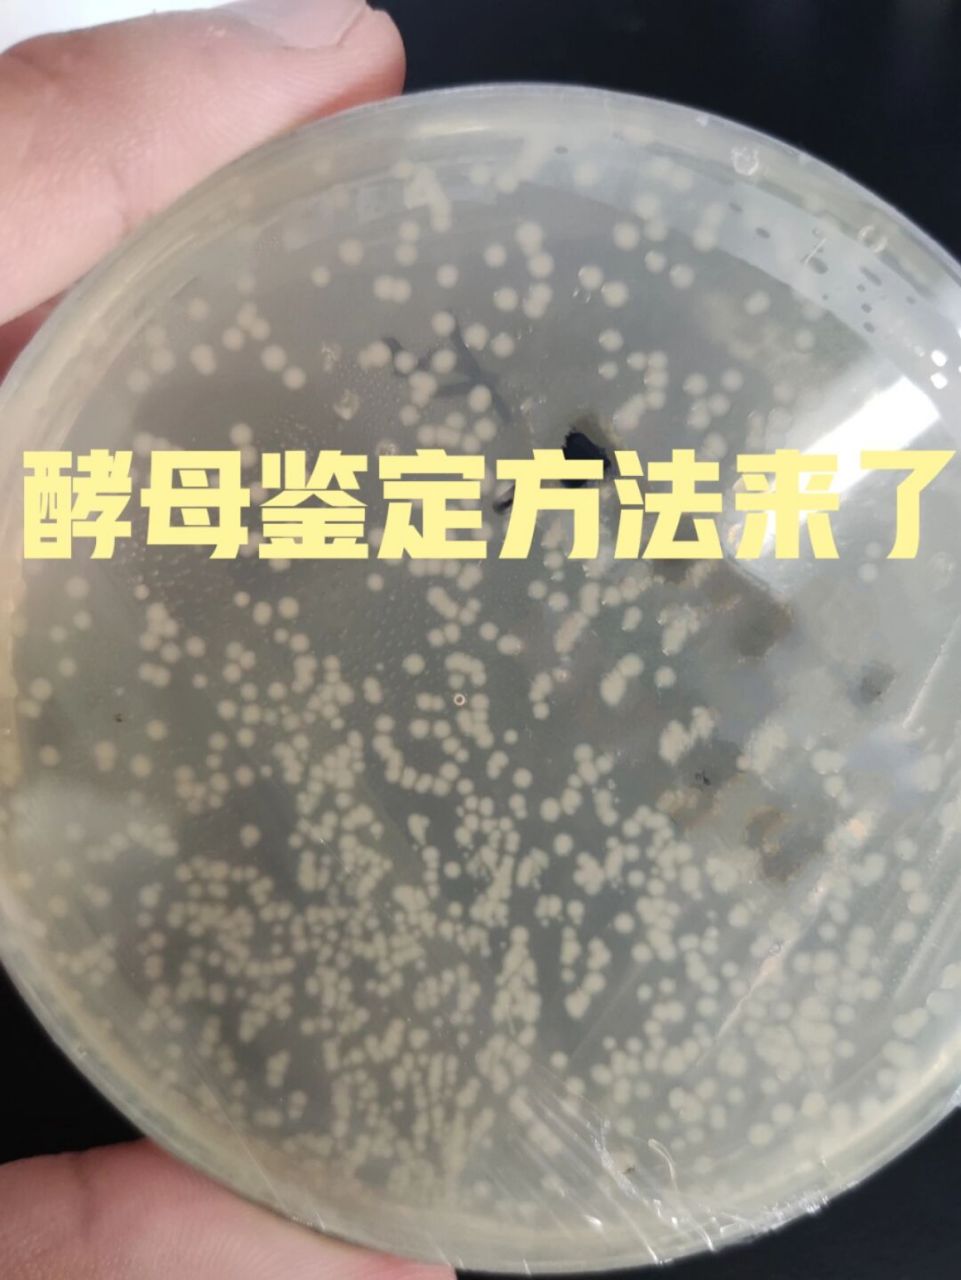
酵母单双杂筛库都需要鉴定,普通的菌落鉴定方法对酵母并不适合,分享几

酿酒酵母菌落形态特征

酵母粉,酵母提取物,酵母浸粉和酵母浸膏的区别您知道吗?
图片尺寸600x529
谁有酵母菌的菌落图片?麻烦传给我看一看!不胜感激!
图片尺寸640x480
酵母菌的菌落
图片尺寸900x430
各种微生物菌落图,您都分得清吗?|细菌|酵母菌|芽孢|培养基_网易订阅
图片尺寸590x782
谁有酵母菌的菌落图片?麻烦传给我看一看!不胜感激!
图片尺寸1632x1224
啤 酒 酵 母 的 菌 落 红 酵 母 的 菌 落 各种酵母菌的菌落
图片尺寸1080x810
酵母单双杂筛库都需要鉴定,普通的菌落鉴定方法对酵母并不适合,分享几
图片尺寸961x1280
3,形态不同(1)酿酒酵母:菌落呈乳白色(生长在麦芽汁琼脂培养基上),有
图片尺寸600x400
(4)菌落特征是鉴定霉菌的重要依据之一.
图片尺寸640x386
所有分类 自然科学 生物学 实验八 酵母菌形态观察ppt 附:酵母菌菌落
图片尺寸1080x810
酵母菌落图
图片尺寸854x640
求大神帮看看我筛出的菌落是不是酵母菌
图片尺寸748x776
孟加拉红培基上酵母菌,细菌菌落的鉴别方法(附图)
图片尺寸623x514
酵母平板菌落照片
图片尺寸500x375
酵母菌细胞
图片尺寸250x350
酿酒酵母菌 奶油色菌落
图片尺寸1000x1000
> 酿酒酵母
图片尺寸1149x647
典型霉菌酵母菌菌落形态
图片尺寸418x404
啤酒酵母菌2
图片尺寸443x374
搞不清酵母菌落观察方法的朋友来看
图片尺寸960x539